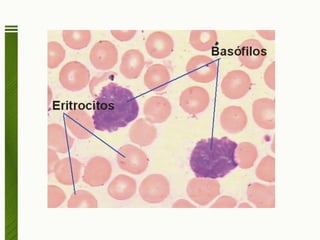

Los mastocitos y basófilos son células inmunes que contienen gránulos con mediadores inflamatorios como la histamina. Juegan un papel importante en las reacciones alérgicas e inflamatorias al expresar receptores FcεRI de alta afinidad para unir IgE. La unión del antígeno a la IgE en estos receptores induce la degranulación de las células y la liberación de mediadores que causan síntomas como los de la anafilaxia.

![Goldsby R, Inmunología 5a ed. Estados Unidos Editorial McGraw Hill, 2004. Parslow T, Stites D, Terr A, Imboden J, Inmunología básica y clínica10a ed. México, Editorial Manual Moderno, 2002 Cinética de rectores [en línea] México. URL disponible en: http://www.uam.es/personal_pdi/medicina/algvilla/receptores/receptores.html](https://image.slidesharecdn.com/35-clulascebadasybasfilos-110322231542-phpapp02/85/35-celulas-cebadas-y-basofilos-34-320.jpg)